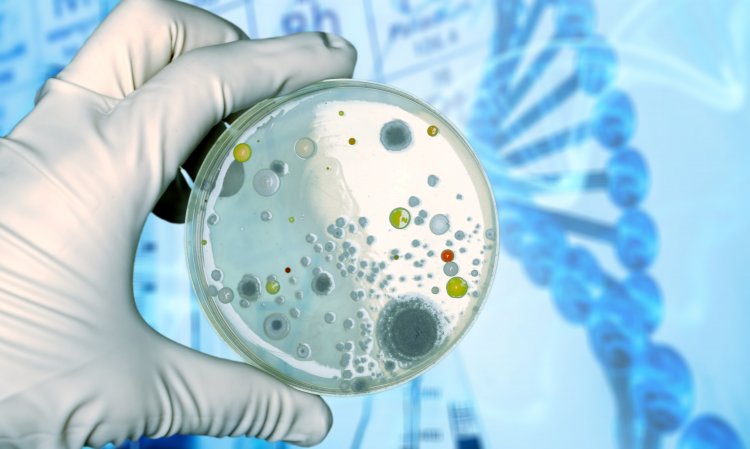

Top Companies in Immunohistochemistry Market by Size, Share, Historical and Future Data & CAGR | Report by Vantage Market Research
Immunohistochemistry Market is expected to reach a value of USD 3.7 Billion by 2030 at a CAGR of 8.6% over the forecast period.
Vantage Market Research has recently published a new report on the "Immunohistochemistry Market” Global Industry Assessment & Forecast to identify key trends and challenges. The report offers insights into the competitive landscape, prospects, and key investment considerations for businesses operating in Immunohistochemistry Market. The key statistics in the report highlight that Global Immunohistochemistry Market was valued at USD 2.1 Billion in 2022 and is expected to reach a value of USD 3.7 Billion by 2030 at a CAGR of 8.6% over the forecast period. The global Immunochemistry Market will continue to expand due to increased demand from end users, Hospitals, Diagnostic labs, and Research institutes.
Request Sample Report of Immunohistochemistry Market @ https://www.vantagemarketresearch.com/immunohistochemistry-market-2132/request-sample
The Global Immunohistochemistry Market is dominated by well-known players like Thermo Fisher Scientific Inc. (U.S.), F. Hoffmann-La Roche Ltd. (Switzerland), Merck KGAA (Germany), Danaher Corporation (U.S.), PerkinElmer Inc. (U.S.), Bio-Rad Laboratories Inc. (U.S.), Cell Signaling Technology Inc. U.S.), Bio S.B. Inc. (U.S.), Agilent Technologies Inc. (U.S.), Abcam PLC (UK), to name a few.
Let’s Take a Look at the Top Market Players that are Captivating the Immunohistochemistry Market
- Thermo Fisher Scientific Inc. (U.S.)

Thermo Fisher Scientific Inc. is an American supplier of scientific instruments, reagents, consumables, and software services. The company serves pharmaceutical companies, biotech companies, academic and research institutions, clinical diagnostic labs, government agencies, and process control sectors. It sells its products and services through a direct sales force, e-commerce, and third-party distributors in the Americas, Asia-Pacific, and Europe. Thermo Fisher is based in Waltham, Massachusetts, after the merger of Thermo Electron and Fisher Scientific in 2006.
- Merck KGAA (Germany)

The Merck Group, is a German multinational science and technology company headquartered in Darmstadt with approximately 60,000 employees and operations in 66 countries. The group includes approximately 250 companies; the main company is Merck KGaA in Germany. The company is divided into three business lines: Healthcare, Life Sciences, and Electronics. Merck is the oldest operating chemical and pharmaceutical companies in the world.
- Danaher Corporation (U.S.)

Danaher Corporation is an American global diversified combination founded by two brothers Stephen and Mitchell Rales in 1984. Danaher Corporation is Headquartered in Washington, DC, they design manufacture, and markets medical, industrial, and commercial products and services. Beckman Coulter Life Sciences is the life sciences businesses of Danaher Corporation, Beckman Coulter Life Sciences is a world leader in research automation, flow cytometry, centrifugation, cell analysis, genomics products, and particle characterization. They provide advanced tools for basic biological research, including the causes of disease, possible promotion of new drug development, and clinical trials.
- PerkinElmer Inc. (U.S)

PerkinElmer, Inc., formerly Perkin-Elmer, is an American global company it provides detection and imaging technologies, consumables, information technology solutions, accessories, and many other services. The company's main products include cytogenetic reagents, ELISA kits, tissue biomarkers, atomic spectroscopy equipment, chromatography equipment, molecular spectroscopy, newborn screening equipment, and thermal analysis equipment. It provides reagents, instruments, analysis platforms, and software to hospitals, doctors, medical laboratories, and medical research professionals. PerkinElmer offers cord blood and tissue banking, laboratory, and research services. Its products are used, for example, in atomic spectroscopy, cell imaging, and analysis, chromatography, analysis and detection, DNA/RNA isolation, in vivo imaging, molecular spectroscopy, protein analysis and detection, and tissue imaging. The company operates in Asia Pacific, Europe, and North America.
- Bio-Rad Laboratories Inc. (U.S)

Bio-Rad Laboratories Inc. is an American company that develops and manufactures specialized technology products for the life sciences research and clinical diagnostics markets. Bio-Rad's life science products primarily include instruments, software, consumables, reagents, and content in the fields of cell biology, gene expression, protein purification, protein quantification, drug development and manufacturing, food safety, and science education. These products are based on techniques for the isolation, purification, detection, analysis, and amplification of biological materials such as antibodies, proteins, nucleic acids, cells, and bacteria. Bio-Rad's diagnostic products and systems use a variety of technologies and provide clinical information in the blood transfusion, diabetes monitoring, and autoimmune and infectious disease markets. These products are used to support the diagnosis, monitoring, and treatment of diseases and other conditions.
- Cell Signaling Technology Inc. (U.S.)

Cell Signaling Technology (CST) is committed to providing the world's highest quality innovative research products to accelerate biological understanding. A privately held company headquartered in Danvers, Massachusetts, USA. Cell Signaling Technology is a mid-sized healthcare company with 500 employees and annual sales of $48.0 million.
- Bio S.B. Inc. (U.S.)

Bio S.B. performs Research and Development (R&D), antibody production, distribution, and Immunohistochemistry (IHC) detection systems, including environmentally friendly accessories, unique IVD-validated antibodies, detection systems, and devices. Our portfolio includes products for Immunohistochemistry (IHC), immunocytochemistry (ICC), immunofluorescence (IF), chromogenic in situ hybridization (CISH), and fluorescent in situ hybridization technology (FISH), which meet the highest international standards in molecular pathology, cancer research, microbiology, immunology, and genetics.
- Agilent Technologies Inc. (U.S.)

Agilent Technologies Inc. is a company headquartered in California that provides instruments, software, services, and supplies for laboratories. Agilent was founded in 1999 as a subsidiary of Hewlett-Packard. Agilent is a market leader in life sciences, diagnostic and applied chemicals. The company provides instruments, services, consumables, applications, and expertise to laboratories around the world to help customers get the information they seek.
- Abcam PLC S.E. (UK)

Abcam PLC. S.E. supplies two-thirds of the world's life scientists with more than 110,000 products to study protein targets in antibodies, proteins, lysates, biochemicals, kits, and assays. They manufacture our products in our specialized facilities around the world and are sourced from more than 400 partners. Abcam PLC. operates as a biotechnology company. The company offers diagnostic, research, and treatment solutions. Abcam serves patients worldwide.
- F Hoffmann-La Roche Ltd. (Switzerland)

F Hoffmann-La Roche AG, commonly known as Roche, is a multinational healthcare company that operates worldwide through two divisions: Pharmaceuticals and Diagnostics. Its holding company, Roche Holding AG, is listed on the Swiss SIX stock exchange. F. Hoffmann-La Roche AG offers in vitro diagnosis and therapy for cancer and organ transplantation. The company specializes in oncology, virology, anti-inflammatory drugs, metabolism, central nervous system, clinical chemistry, immunology, urinalysis, blood tests, genetics, infectious diseases, and microbiology. F. Hoffmann-La Roche operates throughout Switzerland.
Read Our Latest Blog: Top Companies in Abaca Fiber Market
Do You Have Any Queries or Specific Requirements? You may enquire to our sales team before purchasing.
Contact us
Eric Kunz
6218 Georgia Avenue NW Ste 1 - 564
Washington DC 20011-5125
United States Tel: +1 202 380 9727
Email: [email protected]
Website: Vantage Market Research


















